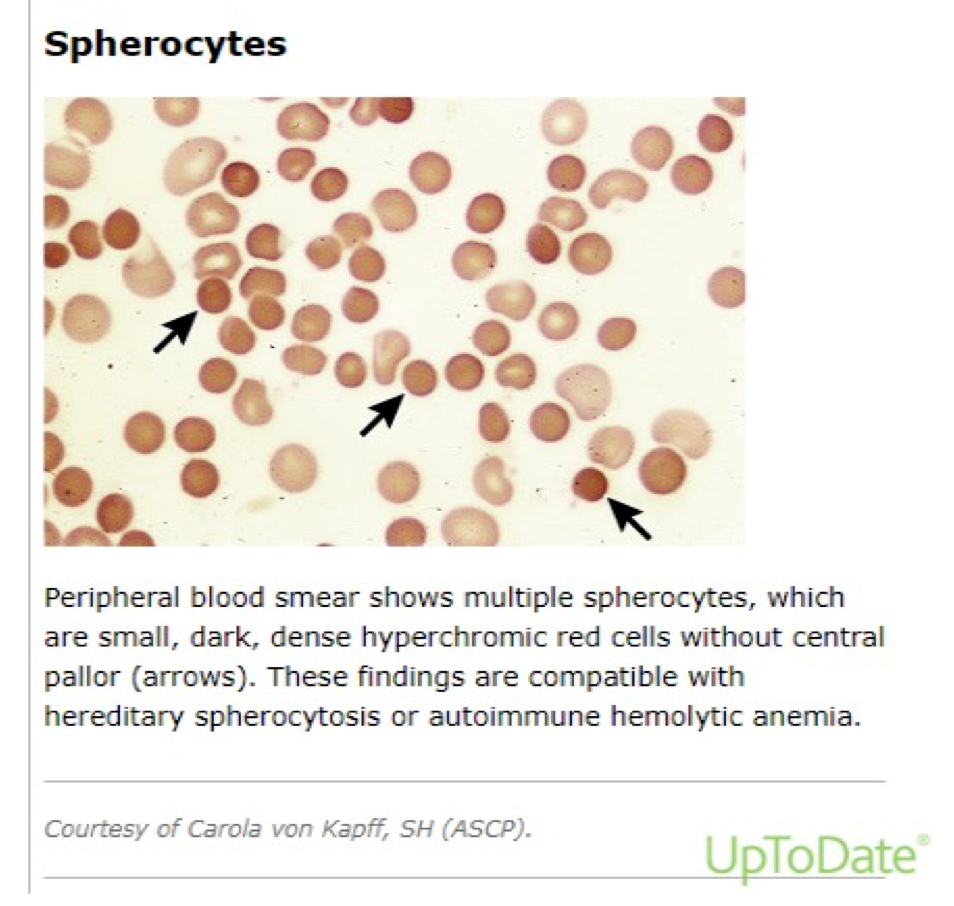

Pediatrics
Red Cell Membrane Defects
- Hereditary Spherocytosis inherited as AD disorder.
- Defect: Deficiency of Beta Spectrin or Ankyrin → Loss of membrane surface area → becomes more spherical → Destruction in Spleen.

“Characterized by Hemolysis, intermittent jaundice, splenomegaly with the spherocytes in the peripheral smear being its morphologic hallmark”.
- May present in the newborn period with anemia and severe hyperbilirubinemia.
- Prone to Aplastic crisis following parvovirus infection, or Megaloblastic Crisis due to folate deficiency.
- Some patients may develop or rarely even present with symptomatic gallstones.
Laboratory Features
- Hb mildly decreased or normal, normal MCV, high MCH content.
- Marked reticulocytosis.
- Peripheral smear: hyperchromatic spherocytes.

Osmotic fragility test
The most common diagnostic screening test used is osmotic fragility test. Red cells in HS show increased osmotic fragility when incubated with hypotonic NaCl solutions in vitro, yielding a diagnostic osmotic fragility curve.
Fresh RBCs are incubated in hypotonic buffered salt solutions of various osmolarities, and the fraction of hemoglobin released (due to hemolysis) is measured. Spherocytic RBCs have reduced surface area to volume (SA/V) ratio.

Neonates with HS
-
Neonates with HS tend to have an elevated MCHC (typical range in HS, 35 to 38 g/dL). This is a useful discriminator between HS and hemolytic disease of the fetus and newborn (HDFN). Increased RDW.
-
EMA binding Assay: high sensitivity; rapid turnaround time (approximately two hours); and need for only a minimal amount of blood (a few microliters), it detects loss mainly of band 3 and Rh-related proteins from the RBC membrane, using EMA, an eosin-based fluorescent dye, that binds to those RBC membrane proteins.
Reduction in fluorescence can be detected in a flow cytometry-based assay.
-
Quantitation of membrane proteins Especially spectrin content is possible by flow cytometric or gel electrophoretic analysis.
-
Osmotic gradient ektacytometry – Osmotic gradient ektacytometry (OGE).
-
Definitive diagnosis of HS can be made on the basis of family history, red cell indices and morphology and a positive screening test.
-
Screen family members: Hereditary spherocytosis can be an autosomal recessive or autosomal dominant trait.
Differential diagnosis of Spherocytes
spherocytes can be observed in other states such as:
- ABO incompatibility
- Immune-mediated hemolytic anemia
- Burns
- Clostridium perfringens sepsis
Management
-
Basic supportive care is advised to all patients.
- Lifelong folate supplementation.
- Prevention of iron deficiency.
- Prompt treatment of infections.
-
Blood transfusion may be required on a regular basis in severe episodes of acute hemolysis, or during aplastic crisis.
-
Erythropoietin may be helpful in reducing the need for transfusion in some infants.
-
Regular follow-up is recommended to monitor growth, spleen size, Hb trend, and occurrence of gallstones.
Surgery
- Autosomal dominant disorder
- Increased permeability of cell membrane to Na, cell swelling & fragility
- **RBC-**spherical, fragile, trapped in spleen & destroyed.
- Excessive haemolysis- jaundice, anaemia, splenomegaly,
- Pigment gallstone formation in 30-60%.
- Spontaneous remission & relapse.
- Haemolytic crisis needs blood transfusion
- Mild cases managed without splenectomy.
- Mild/severe : Splenectomy after age 6 years (risk of OPSI)
- Simultaneous Cholecystectomy if gallstone present